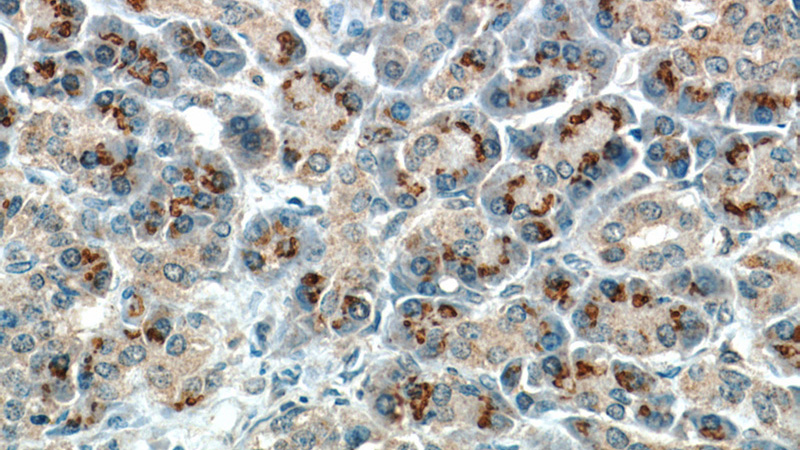

-
Product Name
RPS3 antibody
- Documents
-
Description
RPS3 Mouse Monoclonal antibody. Positive IHC detected in human pancreas tissue, human colon cancer tissue. Positive IF detected in Hela cells. Positive IP detected in HEK-293 cells. Positive WB detected in Human brain, COLO 320 cells, HeLa cells. Observed molecular weight by Western-blot: 33kD
-
Tested applications
ELISA, WB, IHC, IF, IP
-
Species reactivity
Human; other species not tested.
-
Alternative names
40S ribosomal protein S3 antibody; FLJ26283 antibody; FLJ27450 antibody; ribosomal protein S3 antibody; RPS3 antibody
-
Isotype
Mouse IgG2a
-
Preparation
This antibody was obtained by immunization of RPS3 recombinant protein (Accession Number: NM_001256802). Purification method: Protein A purified.
-
Clonality
Monoclonal
-
Formulation
PBS with 0.02% sodium azide and 50% glycerol pH 7.3.
-
Storage instructions
Store at -20℃. DO NOT ALIQUOT
-
Applications
Recommended Dilution:
WB: 1:500-1:5000
IP: 1:1000-1:10000
IHC: 1:20-1:200
IF: 1:10-1:100
-
Validations

human brain tissue were subjected to SDS PAGE followed by western blot with Catalog No:107510(RPS3 antibody) at dilution of 1:1000
Immunohistochemical of paraffin-embedded human pancreas using Catalog No:107510(RPS3 antibody) at dilution of 1:50 (under 40x lens)

Immunofluorescent analysis of Hela cells, using RPS3 antibody Catalog No: at 1:25 dilution and Rhodamine-labeled goat anti-mouse IgG (red).

IP Result of anti-RPS3 (IP:Catalog No:107510, 3ug; Detection:Catalog No:107510 1:2000) with HEK-293 cells lysate 1800ug.
-
Background
40S ribosomal protein S3 (RPS3), also named as SW-cl.26, is a 243 amino acid protein,which contains one KH type-2 domain and belongs to the ribosomal protein S3P family. RPS3 localizes in the cytoplasm. RPS3 is identified in a IGF2BP1-dependent mRNP granule complex, which contains untranslated mRNAs. RPS3 plays a role in repairing various DNA damage acting as a repair UV endonuclease. Nuclear accumulation of RPS3 results in an increase in DNA repair activity to some extent, thereby sustaining neuronal survival.
-
References
- Nagao-Kitamoto H, Setoguchi T, Kitamoto S. Ribosomal protein S3 regulates GLI2-mediated osteosarcoma invasion. Cancer letters. 356(2 Pt B):855-61. 2015.
- Iida R, Ueki M, Yasuda T. Identification of interacting partners of Human Mpv17-like protein with a mitigating effect of mitochondrial dysfunction through mtDNA damage. Free radical biology & medicine. 87:336-45. 2015.
Related Products / Services
Please note: All products are "FOR RESEARCH USE ONLY AND ARE NOT INTENDED FOR DIAGNOSTIC OR THERAPEUTIC USE"
